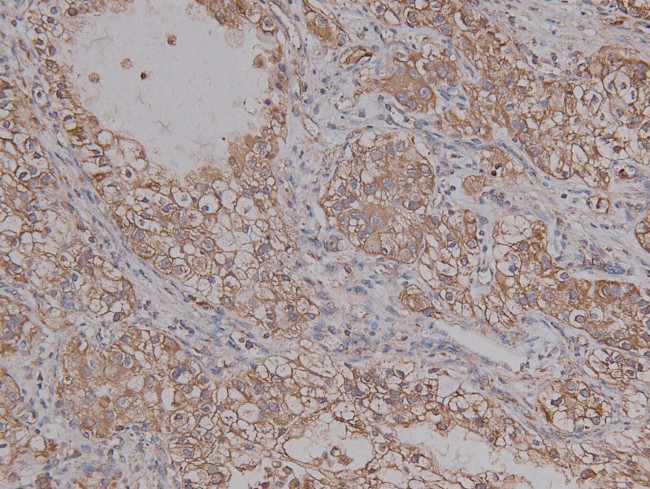
Phospho-PKA alpha (Ser339) Antibody in Immunohistochemistry (Paraffin) (IHC (P))

Search
Invitrogen
Phospho-PKA alpha (Ser339) Polyclonal Antibody
{{$productOrderCtrl.translations['antibody.pdp.commerceCard.promotion.promotions']}}
{{$productOrderCtrl.translations['antibody.pdp.commerceCard.promotion.viewpromo']}}
{{$productOrderCtrl.translations['antibody.pdp.commerceCard.promotion.promocode']}}: {{promo.promoCode}} {{promo.promoTitle}} {{promo.promoDescription}}. {{$productOrderCtrl.translations['antibody.pdp.commerceCard.promotion.learnmore']}}
图: 1 / 4
Phospho-PKA alpha (Ser339) Antibody (PA5-118607) in IHC (P)




产品信息
PA5-118607
宿主/亚型
分类
类型
抗原
偶联物
形式
浓度
保存条件
运输条件
RRID
靶标信息
Protein kinase A (PKA, cAMP-dependent protein kinase) is a key element of a ubiquitous signaling pathway important in the cell cycle, cellular communication, memory formation and behavior. PKA is composed of two catalytic (PKAc; Protein Kinase A catalytic subunit) and two regulatory subunits (PKAr). Upon binding cAMP, the complex dissociates to PKAr dimer and two activated PKAc ser/thr protein kinase catalytic monomers. The released PKAc can translocate into the nucleus and exert a regulatory role in the activation of multiple nuclear hormone receptors. However, PKAc-mediated activation of tonicity-dependent gene expression is cAMP independent. Humans express three types of PKAc subunit - PKAc alpha is present in most human tissues, PKAc beta and gamma are tissue-specific, the later is found in testes.
仅用于科研。不用于诊断过程。未经明确授权不得转售。